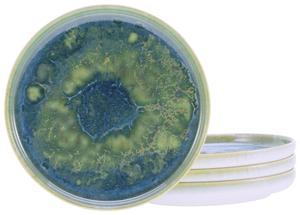
Тарелка Creatable синий, зеленый диаметр: 17,5 см

Creatable
1486 товаров
1486 товаров